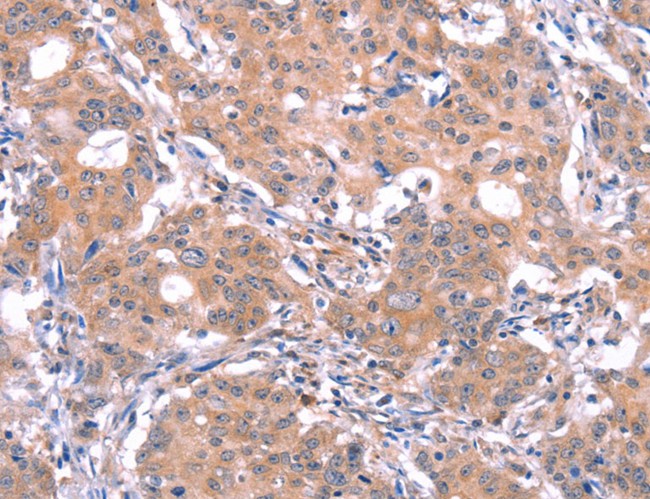
product-image-AAA170780_IHC11.jpg

Rabbit anti-Mouse rat GABAA Receptor a 1 Polyclonal Antibody | anti-GABRA1 antibody
Anti-GABAA Receptor, alpha1-Subunit
Reactivity
Mouse rat
Applications
Immunohistochemistry, Dot Blot, Western Blot
Purity
Affinity Purified (Prepared from rabbit serum by affinity purification using a column to which the fusion protein immunogen was coupled.)
Synonyms
GABAA Receptor a 1, Antibody; Anti-GABAA Receptor, alpha1-Subunit; anti-GABRA1 antibody
Host
Rabbit
Reactivity
Mouse rat
Clonality
Polyclonal
Specificity
Specific for the ~51k alpha1-subunit of the GABAA-R in Western blots of rat brain membrane fractions. Also recognizes the Alpha1-subunit of the GABAA-R in bovine, human and mouse brain extracts.
Purity/Purification
Affinity Purified (Prepared from rabbit serum by affinity purification using a column to which the fusion protein immunogen was coupled.)
Form/Format
100 ul in 10 mM HEPES (pH 7.5), 150 mM NaCl, 100 ug per ml BSA and 50% glycerol. Adequate amount of material to conduct 10-mini Western Blots.
Sequence Length
455
Applicable Applications for anti-GABRA1 antibody
IHC (Immunohistochemistry), DB (Dot Blot), WB (Western Blot)
Antigen
Fusion protein from the cytoplasmic loop of the alpha1-subunit of rat GABAA receptor.
Immunogen Information
Fusion protein from the cytoplasmic loop of the alpha 1 subunit
Immunogen Species
Rat
Reactivity Assumed Based on 100% Sequence Homology
Bovine, canine, human, mouse non-human primate
Species Reactivity Note
The antibody has been directly tested for reactivity in Western blots with mouse and rat tissue. It is anticipated that the antibody will react with bovine, canine, human, and non-human primate based on the fact that these species have 100% homology with the amino acid sequence used as antigen.
Biological Significance
Gamma-aminobutyric acid (GABA) is the primary inhibitory neurotransmitter in the central nervous system, causing a hyperpolarization of the membrane through the opening of a Cl- channel associated with the GABAA receptor (GABAA-R) subtype. GABAA-Rs are important therapeutic targets for a range of sedative, anxiolytic, and hypnotic agents and are implicated in several diseases including epilepsy, anxiety, depression, and sub-stance abuse. The GABAA-R is a multimeric subunit complex. To date six alphas, four betas and four gammas, plus alternative splicing variants of some of these subunits, have been identified (Olsen and Tobin, 1990; Whiting et al., 1999; Ogris et al., 2004). Injection in oocytes or mammalian cell lines of cRNA coding for alpha- and beta-subunits results in the expression of functional GABAA-Rs sensitive to GABA. However, coexpression of a gamma-subunit is required for benzodiazepine modulation. The various effects of the benzodiazepines in brain may also be mediated via different alpha-subunits of the receptor (McKernan et al., 2000; Mehta and Ticku, 1998; Ogris et al., 2004; Pöltl et al., 2003).
Preparation and Storage
For long term storage -80 degree C is recommended, but shorter term storage at -20 degree C is also acceptale as aliquots may be taken without freeze/thawing due to the presence of 50% glycerol. Stock solutions are stable for a minimum of 1 year at -20 degree C.
Related Product Information for anti-GABRA1 antibody
Affinity purified rabbit polyclonal antibody
References
• McKernan RM, et al. (2000) Sedative but not anxiolytic properties of benzodiazepines are mediated by the GABAA receptor alpha1-subtype. Nature Neurosci 3:587-592.
• Mehta AK, Ticku MK (1998) Prevalence of the GABAA receptor assemblies containing alpha1-subunit in the rat cerebellum and cerebral cortex as determined by immunoprecipitation: Lack of modulation by chronic ethanol administration. Mol Brain Res 67:194-199.
• Ogris W, Pöltl A, Hauer B, Ernst M, Oberto A, Wulff P, Höger H, Wisden W, Sieghart W (2004) Affinity of various benzodiazepine site ligands in mice with a point mutation in the GABAA receptor gamma2-subunit. Biochem Pharmacol 68:1621-1629.
• Mridula Rewal, Rachel Jurd, T. Michael Gill, Dao-Yao He, Dorit Ron, and Patricia H. Janak (2009) 4-Containing GABAA Receptors in the Nucleus Accumbens Mediate Moderate Intake of Alcohol J. Neurosci., 29: 543 - 549
• Olsen RW, Tobin AJ (1990) Molecular biology of GABAA receptors. FASEB 4:1469-1480.
• Mehta AK, Ticku MK (1998) Prevalence of the GABAA receptor assemblies containing alpha1-subunit in the rat cerebellum and cerebral cortex as determined by immunoprecipitation: Lack of modulation by chronic ethanol administration. Mol Brain Res 67:194-199.
• Ogris W, Pöltl A, Hauer B, Ernst M, Oberto A, Wulff P, Höger H, Wisden W, Sieghart W (2004) Affinity of various benzodiazepine site ligands in mice with a point mutation in the GABAA receptor gamma2-subunit. Biochem Pharmacol 68:1621-1629.
• Mridula Rewal, Rachel Jurd, T. Michael Gill, Dao-Yao He, Dorit Ron, and Patricia H. Janak (2009) 4-Containing GABAA Receptors in the Nucleus Accumbens Mediate Moderate Intake of Alcohol J. Neurosci., 29: 543 - 549
• Olsen RW, Tobin AJ (1990) Molecular biology of GABAA receptors. FASEB 4:1469-1480.
NCBI and Uniprot Product Information
NCBI GI #
NCBI GeneID
NCBI Accession #
NCBI GenBank Nucleotide #
Molecular Weight
51
NCBI Official Full Name
gamma-aminobutyric acid receptor subunit alpha-1
NCBI Official Synonym Full Names
gamma-aminobutyric acid (GABA) A receptor, alpha 1
NCBI Official Symbol
Gabra1
NCBI Protein Information
gamma-aminobutyric acid receptor subunit alpha-1; GABA(A) receptor subunit alpha-1; gamma-aminobutyric acid A receptor, alpha 1; gamma-aminobutyric acid A receptor, alpha 1; gamma-aminobutyric acid (GABA-A) receptor, subunit alpha 1
UniProt Protein Name
Gamma-aminobutyric acid receptor subunit alpha-1
UniProt Gene Name
Gabra1
UniProt Synonym Gene Names
Gabra-1
UniProt Entry Name
GBRA1_RAT
Customer Reviews
Loading reviews...
Share Your Experience
Similar Products
Product Notes
The GABRA1 gabra1 (Catalog #AAA72788) is an Antibody produced from Rabbit and is intended for research purposes only. The product is available for immediate purchase. The Anti-GABAA Receptor, alpha1-Subunit reacts with Mouse rat and may cross-react with other species as described in the data sheet. AAA Biotech's GABAA Receptor a 1 can be used in a range of immunoassay formats including, but not limited to, IHC (Immunohistochemistry), DB (Dot Blot), WB (Western Blot). Researchers should empirically determine the suitability of the GABRA1 gabra1 for an application not listed in the data sheet. Researchers commonly develop new applications and it is an integral, important part of the investigative research process. It is sometimes possible for the material contained within the vial of "GABAA Receptor a 1, Polyclonal Antibody" to become dispersed throughout the inside of the vial, particularly around the seal of said vial, during shipment and storage. We always suggest centrifuging these vials to consolidate all of the liquid away from the lid and to the bottom of the vial prior to opening. Please be advised that certain products may require dry ice for shipping and that, if this is the case, an additional dry ice fee may also be required.Precautions
All products in the AAA Biotech catalog are strictly for research-use only, and are absolutely not suitable for use in any sort of medical, therapeutic, prophylactic, in-vivo, or diagnostic capacity. By purchasing a product from AAA Biotech, you are explicitly certifying that said products will be properly tested and used in line with industry standard. AAA Biotech and its authorized distribution partners reserve the right to refuse to fulfill any order if we have any indication that a purchaser may be intending to use a product outside of our accepted criteria.Disclaimer
Though we do strive to guarantee the information represented in this datasheet, AAA Biotech cannot be held responsible for any oversights or imprecisions. AAA Biotech reserves the right to adjust any aspect of this datasheet at any time and without notice. It is the responsibility of the customer to inform AAA Biotech of any product performance issues observed or experienced within 30 days of receipt of said product. To see additional details on this or any of our other policies, please see our Terms & Conditions page.Item has been added to Shopping Cart
If you are ready to order, navigate to Shopping Cart and get ready to checkout.